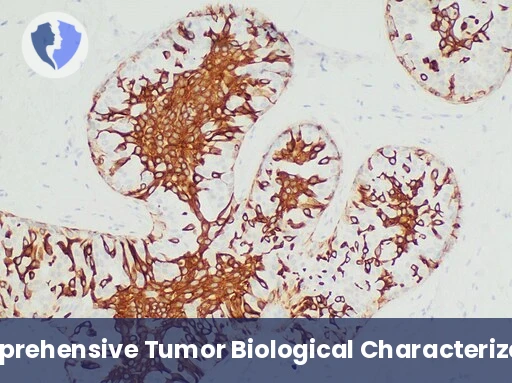
Biological Profile & Therapy Consultation - Immunohistochemistry (IHC) Interpretation and Consultation (5 Mark

Service Details
Biological Profile & Therapy Consultation - Immunohistochemistry (IHC) Interpretation and Consultation (5 Markers)
A comprehensive therapeutic consultation package is provided, based on the systematic biological characterization of the tumor using five immunohistochemical (IHC) markers selected to cover the key areas: 1) classification and diagnosis, 2) therapeutic receptors (hormonal/targeted), 3) proliferation status, 4) immune response, and 5) an additional prognostic or differential marker. The quintuple profile is analyzed within the framework of current treatment guidelines (such as NCCN and ESMO) by a pathologist to produce a consultation report that directly links each potential treatment outcome to a specific marker, with options weighted based on the strength of the evidence.